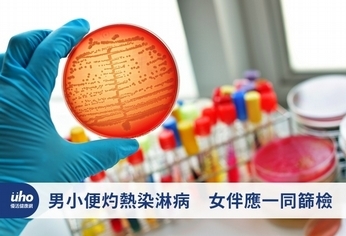

(優活健康網記者黃苡安/綜合報導)一名戴口罩的年輕人,在門診等候區滑著手機,進入診間馬上焦急的詢問:「醫師,我這幾天尿尿時感覺灼熱疼痛,分泌物也比較多,上網google好像是……」醫師仔細詢問病史後,判斷需進行身體檢查,年輕人一脫下長褲,醫生發現內褲上沾有許多黃白色的膿液。免疫力差恐引發腦膜炎這是泌尿科診間常見的情景,台北市立聯合醫院忠孝院區泌尿科醫師莊梓昱表示,年輕男性患者近期有性接觸史,排尿時有明顯灼痛感,合併尿道口有分泌物,需要高度懷疑是性傳染病引起的尿道炎。這樣的情況可以分成兩類:淋病性尿道炎及非淋病性尿道炎。以淋病為例,男子性行為後約2至7天出現尿道黃綠色膿性分泌物,少數免疫力較差的患者,甚至會出現心內膜炎或腦膜炎等嚴重併發症,診斷是以細菌培養或蒐集分泌物進行檢查;而非淋病性尿道炎則以披衣菌感染為大宗,尿道分泌物較為半透明,排尿刺痛,若不留意後續可能形成副睪炎。男性會尿道化膿 女性症狀不明顯也應篩檢淋病主要影響生殖系統,男性感染後2至7天會出現尿道化膿,排尿有刺痛或灼熱感等症狀;女性感染後大多不會有疼痛感,症狀也不明顯,因此常被忽略,若沒有及時接受治療,不論男性或女性,都可能會造成不孕。因此,男性患者最好能帶著發病前10天有過性接觸的伴侶一同前來篩檢。疾管署分析發現,常用口服抗生素Ciprofloxacin的抗藥性高達95%,另一種常用口服抗生素Azithromycin也已被發現產生具抗藥性菌株(37株,2%)。建議醫師治療淋病務必選擇針劑抗生素以肌肉注射治療,勿單獨使用口服抗生素以免治療失敗。且須注意在治療期間禁止性行為。疾管署呼籲,為防止淋病無藥可醫,民眾應避免參加轟趴及性派對,或有多重性伴侶等危險性行為、拒絕使用成癮性藥物,發生性行為時,應全程正確使用保險套並搭配水性潤滑液。民眾如出現疑似症狀或懷疑感染,勿自行買藥或誤信偏方,應立即就醫。